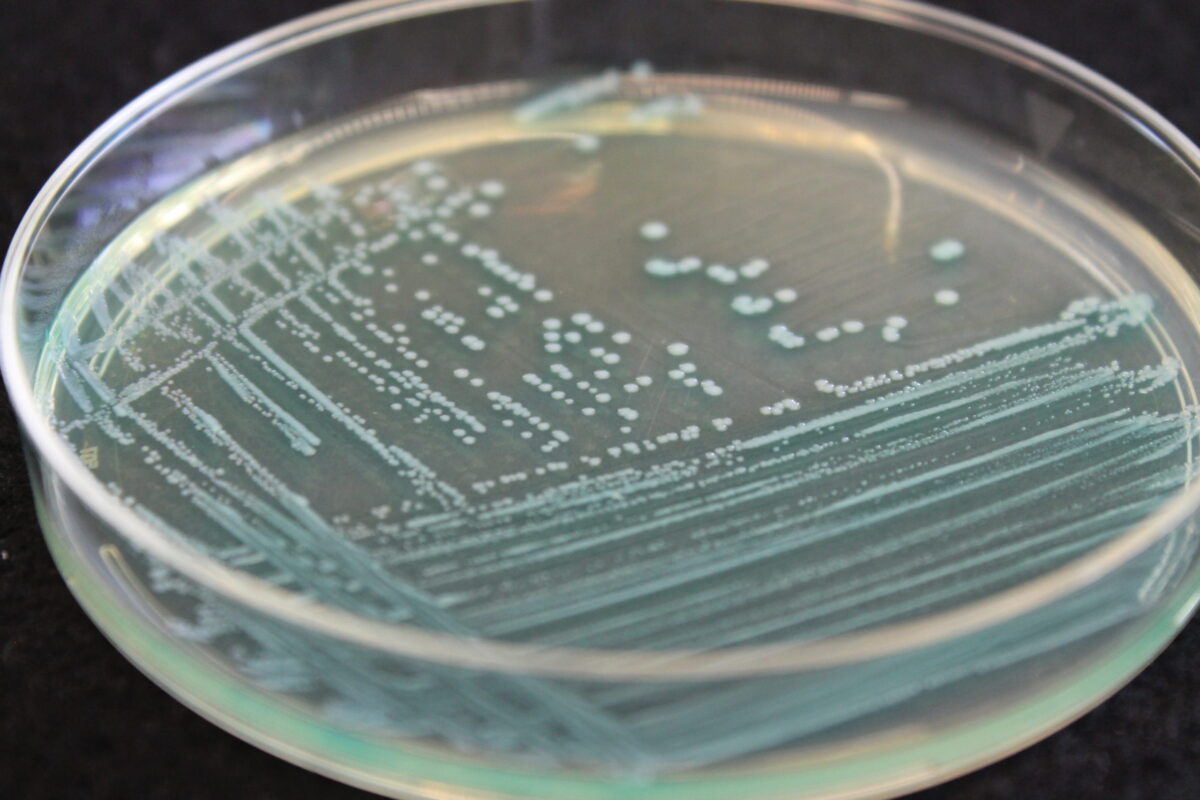

Column: Tackling listeria, our produce safety greatest common denominator
In managing my company’s fresh produce processing business, I consider two focus areas to be critical: managing risk and growing consumption. Food safety is foundational to both.
In managing my company’s fresh produce processing business, I consider two focus areas to be critical: managing risk and growing consumption. Food safety is foundational to both.
I can’t think of a more potentially catastrophic risk than a food safety problem; they can be terminal for a company. Meanwhile, a food safety issue can disrupt consumer confidence and lower consumption.
For fresh produce processors, Listeria monocytogenes is our greatest common denominator foodborne pathogen. While some of us have issues with salmonella, some with E. coli, listeria is at home in all our environments: cold, wet, hidden, hard to access. It can take up residence on our harvest, packing and processing equipment, and in our facilities. There, it can persist and potentially cross-contaminate our fresh foods over extended periods of time.
Yet we have more questions than answers about listeria, the Center for Produce Safety (CPS) is working to remedy that.
To date, CPS has invested $4.8 million in 26 listeria-centric research projects at 14 institutions, in the U.S. and abroad. CPS is working hard to give us learnings about Lm survival, growth, mitigation and prevention that we can apply to our real-world businesses. I think that with CPS’s help, we can rapidly gain an upper hand on listeria.
Virginia Tech’s Laura Strawn, Ph.D., described her team’s learnings about Lm survival and growth during a June 23, 2020 webinar. They began by evaluating the science literature to learn what’s known about Lm and fresh produce. They then conducted laboratory studies to fill knowledge gaps about Lm survival on fresh produce. They found that Lm survival varied depending upon the commodity and its surface, holding conditions and initial pathogen load; for this pathogen, temperature control is the most critical driver. Using Strawn’s data, Rutgers’ Don Schaffner, Ph.D., then modeled Lm survival and growth. He found that the open-access food microbiology database Combase is generally reliable for forecasting listeria risk for fresh produce, excluding tomatoes.
Cal Poly’s Amanda Lathrop, Ph.D., reported during a June 30, 2020 webinar her CPS-funded learnings about Lm growth and survival on nontraditional greens, including beet greens, kale, Brussels sprouts and shredded broccoli stalks. (Research to date has focused on traditional leafy greens.) They documented the growth of an Lm surrogate on foods stored at various temperatures; their findings can help processors assess our Lm risk if we lose temperature control. We also learned that for these foods, physical abuse during storage and distribution does not significantly increase risk beyond what results from chopping, slicing or shredding.
Cornell’s Martin Wiedmann, Ph.D., reported in a June 29, 2021 webinar about a CPS-funded study into likely places in fresh produce facilities where Lm can persist, or be persistently transient. Wiedmann reported his surprise at some of those places — not only catch pans, waxing equipment and floor/wall junctures, but also forklifts, forklift stops and stickers on equipment. And while research to date has largely focused on preventing listeria, Wiedmann’s team evaluated ways to mitigate it. We should all note that they found deep cleaning alone isn’t enough.
Then does our future lie in emerging technologies to destroy listeria? Preliminary findings from CPS-funded research by University of Georgia’s Francisco Diez-Gonzalez, Ph.D., indicates that antimicrobial blue light can destroy Lm on stainless steel surfaces. At CPS’s 2022 Research Symposium, he will present final findings about the role this new tech might play to improve the microbial safety of fresh produce packing and processing facilities.
These are just a few of the listeria learnings from CPS’s research reservoir. We also know that aggressive cleaning and sanitation programs, combined with environmental monitoring for the pathogen, can help control listeria risks. We know we should design equipment and facilities for easy cleaning and sanitation. We know that computer models can help predict Lm persistence and growth across our distribution chain.
Food safety should be non-negotiable to a company’s values, culture and success. We can never be done learning — and that’s where Center for Produce Safety comes in. Center for Produce Safety is the fresh produce industry’s center pivot on fresh produce food safety. My company tries to glean as much information as possible from CPS. And we push CPS to help us learn how to apply their learnings to protect our business. I deeply respect the talent that CPS has assembled, and the passion that people within our industry put into CPS’s produce-centric food safety research mission.
If you aren’t already tapping into CPS’s research resources, start today. And if you aren’t already financially supporting CPS’s work, contribute to the research capital campaign underway now. You can do both at centerforproducesafety.org.
— Steve Kenfield has led the value-added ready-to-eat grape business for HMC Farms, a vertically integrated company headquartered in California with operations on both hemispheres, and a reputation for innovation and execution. He is a longtime member of Center for Produce Safety’s volunteer Board of Directors, which keeps CPS focused on its mission: to fund the science needed to find solutions and fuel change in fresh produce food safety.
